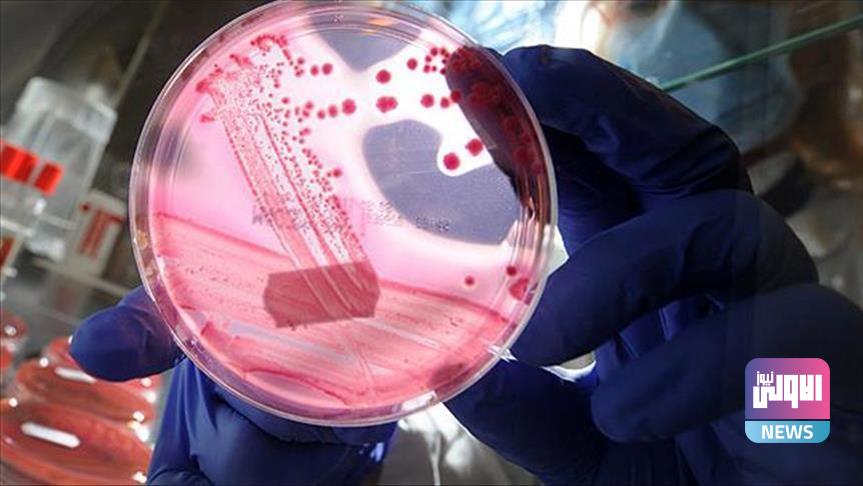

إصابات بالكوليرا في دول عربية ومخاوف من انتشاره
اطلعت وكالة (الاولى نيوز) على تقرير تطرق لقضية انتشار حالات الإصابة بمرض الكوليرا في عدد من الدول العربية والخطوات المتخذة لاحتوائه والحد من تزايد أعداد المصابين.
استهل الدكتور رياض عربي درقاوي، أخصائي الطب المخبري والمناعة، حديثه بالتأكيد على أنه لا يوجد دولة يمكنها إجراء إحصائية دقيقة لعدد المصابين، وذلك يعود إلى أن 25% من المصابين تظهر لديهم الأعراض فقط، وتابع الدكتور درقاوي أن هناك نحو 15% من الفئة التي يبدو عليها المرض ستصبح الأعراض لديهم شديدة، كالأطفال والمسنين الذين لا يملكون جهازا مناعيا قويا، وهنا يجب الانتباه عند ظهور الأعراض كالإقياء والإسهال الشديد.
أضاف الدكتور رياض أن التوعية هي الأساس للحد من انتشار هذا المرض، في الصحف والتلفزيون، إضافة لضرورة تلقي اللقاح المتاح لكافة الأعمار، متابعا أنه يجب على الجهات المسؤولة العمل على تعقيم المياه المستخدمة في الشرب وغسل المواد الغذائية قدر الإمكان، إضافة لعدم إهمال أي أعراض تظهر على الشخص ومراجعة الطبيب لعلاج المرض في مراحله الأولى.
وقد سجلت دول عربية مثل سوريا، لبنان، العراق واليمن أعدادا من الإصابات بمرض الكوليرا، بالتزامن مع تحذيرات منظمة الصحة العالمية من انتشار أوسع للوباء إذا لم يتم تدارك الوضع.
الاولى نيوز-متابعة